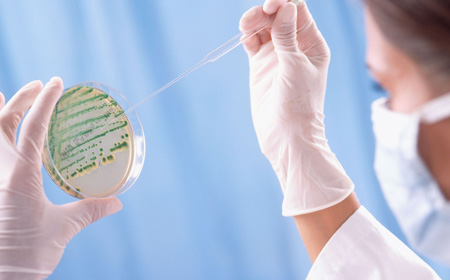

Neue Ansätze zur Knorpelheilung
Stiftungsprofessur mit insgesamt 1,5 Millionen Euro gefördert
Kaputte Gelenke! Knorpelschaden! Wie oft hören Arthrose-Betroffene diese Worte von ihrem Arzt, wenn er ihnen die Diagnose Arthrose stellt. Jeder Arthrose – mit all ihren Schmerzen und Sorgen – liegt stets ein Schaden der Knorpelschicht des Gelenks zugrunde. Wie unendlich dankbar wären Betroffene, wenn es möglich wäre, den geschädigten Gelenkknorpel wieder zu heilen! Um diesem großen Ziel näher zu kommen, wurde am Universitäts-Klinikum Homburg eine hoffnungsvolle Stiftungsprofessur zur Grundlagenforschung eingerichtet.
Warum heilen Knorpelschäden so schwer? Jede einzelne Knorpelzelle ist von einem Gerüst aus jenen wasserbindenden Stoffen umgeben, die dem Knorpel seine besondere Elastizität verleihen. Wenn diese feine arkadenförmige Struktur im Inneren des Knorpels zerstört ist, kann sie nur ganz schwer wieder aufgebaut werden. Ein noch größeres Hindernis für ihre Heilung ist aber, dass sich Knorpelzellen nur sehr langsam teilen und neu bilden können. Von großer Bedeutung sind daher Forschungsarbeiten, die Methoden entwickeln, um diesen Heilungsprozess zu beschleunigen.
Aufbauend auf Forschungen der renommierten Harvard-Universität in Boston, USA, arbeiten der erfahrene Gelenkforscher Herr Prof. Madry und sein Team an diesem großen Ziel. Mit Hilfe moderner zellbiologischer Methoden versuchen sie, die Heilung der erkrankten Knorpelschicht biologisch anzuregen und zu beschleunigen, sodass neu gebildeter Knorpel den freiliegenden Gelenkknochen wieder bedecken und ihm Schutz geben kann.
Projektleitung: Herr Professor Dr. med. H. Madry, Direktor des Zentrums für Experimentelle Orthopädie am Universitäts-Klinikum Homburg